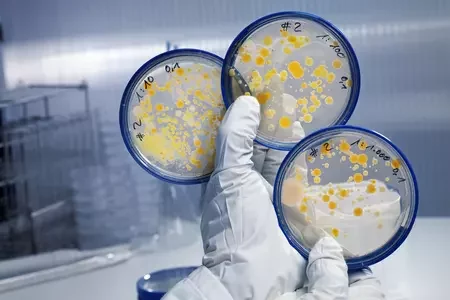

Статьи за 21 октября 2024

Маляваныч рассказал, сколько у него украли телефонные мошенники и почему поверил им20

«В ZUS округлили глаза: они никогда о таком не слышали». Как белорусы переводили пенсию из Беларуси в Польшу5

Зимнюю форму минских гаишников также поменяли ФОТО5

В минском парке Горького собираются сносить «Сказочный замок»1

Умер бывший солист Iron Maiden2

«Продал маме фиктивно». Белорусы рассказали, с каким трудом продают свои квартиры3

На рынке продавали мухоморы. А что, так можно?5

На берегу Нарочи появились «космические» купола со всеми удобствами. Что это за диво?1

В Судане сбили грузовой самолет с россиянами на борту4

Российский лоукостер перестает летать в Беларусь

«Мои силы закончились»: Валерина Кустова рассказала, почему собирает на помощь своей семье40

В Албании арестовали бывшего президента

Вышло «Убийство в Восточном экспрессе» по-белорусски

Белоруска написала о нелюбви людей читать книги. Тред собрал миллион просмотров и шквал хейта12

В Италии погиб 15-летний сын белоруски. Возможно, это из-за буллинга8

Китай вводит контроль над экспортом товаров двойного назначения на фоне войны в Украине

Изменения в транспортном налоге — появится больше льготников, а состоятельным наоборот придется раскошелиться

«Чтобы снег ровно лег». В Гомеле показали покос осенней листвы1

Депутат рассказал чиновникам в Осиповичах, чем древняя магия отличается от современной9

Лукашенко назначил посла в Словакии

Признали политзаключенными еще 8 человек

Беларусь попала в список стран с самым дешевым пивом в мире

За участие в акциях протеста задержали супругов

Белоруска устроилась в Варшаве на работу зазывалой. Что она делает и сколько зарабатывает?4
Ученые бьют тревогу — антибиотики перестают работать4

Мир на пороге неизбежного глобального долгового кризиса: как это грозит разрушить наше будущее?6

Казахстан выдаст Беларуси гражданина Кыргызстана, обвиняемого в убийстве

«Улыбнулся и доброжелательно кивнул». Могилевский епископ рассказал, о чем он разговаривал с папой в Ватикане

Израильская девушка спаслась во время нападения ХАМАСа на фестиваль, но через год покончила жизнь самоубийством27

В Могилевской области выловили 15-килограммовую щуку — ее доставали из воды почти час

Жителя Бобруйска после возвращения из Польши осудили на 7 лет колонии якобы за создание двух телеграм-чатов

«Погружение в отечественные корни». Белорусам вместо туров по Евросоюзу предложат поездки в Смоленск, Псков и Калугу8

«Знаем мы ваши интернеты». Активист установил на польско-белорусской границе плакат с информацией о репрессиях в Беларуси4

Лукашенко хочет, чтобы белорусы строили жилье в неперспективных деревнях9
Зрители Театра кукол уходят, не досмотрев спектакль. Почему?

Змитер Дашкевич сказал, что нужно делать белорусам сейчас, чтобы страна стала свободной и независимой

Деньги белоруса 10 лет лежали в банке на депозите. Что с ними стало за это время?

Вынесли приговор Полине Зыль — блогеру, которая стала нулевым пациентом дела Гаюна, так как у нее нашли ту самую ссылку от Мотолько

В Варшаве белорусы празднуют День Воли ФОТО

Бывшие жена и девушка Протасевича объединились и пришли к его новой невесте, чтобы отомстить. И угрожают судом

Известная певица и ее муж из Беларуси перевели на лечение трехлетней Ксюши с СМА сразу более 100 тысяч евро

Эта актриса получила больше всего «Оскаров» в истории — но никогда не приходила их получать

ещё →